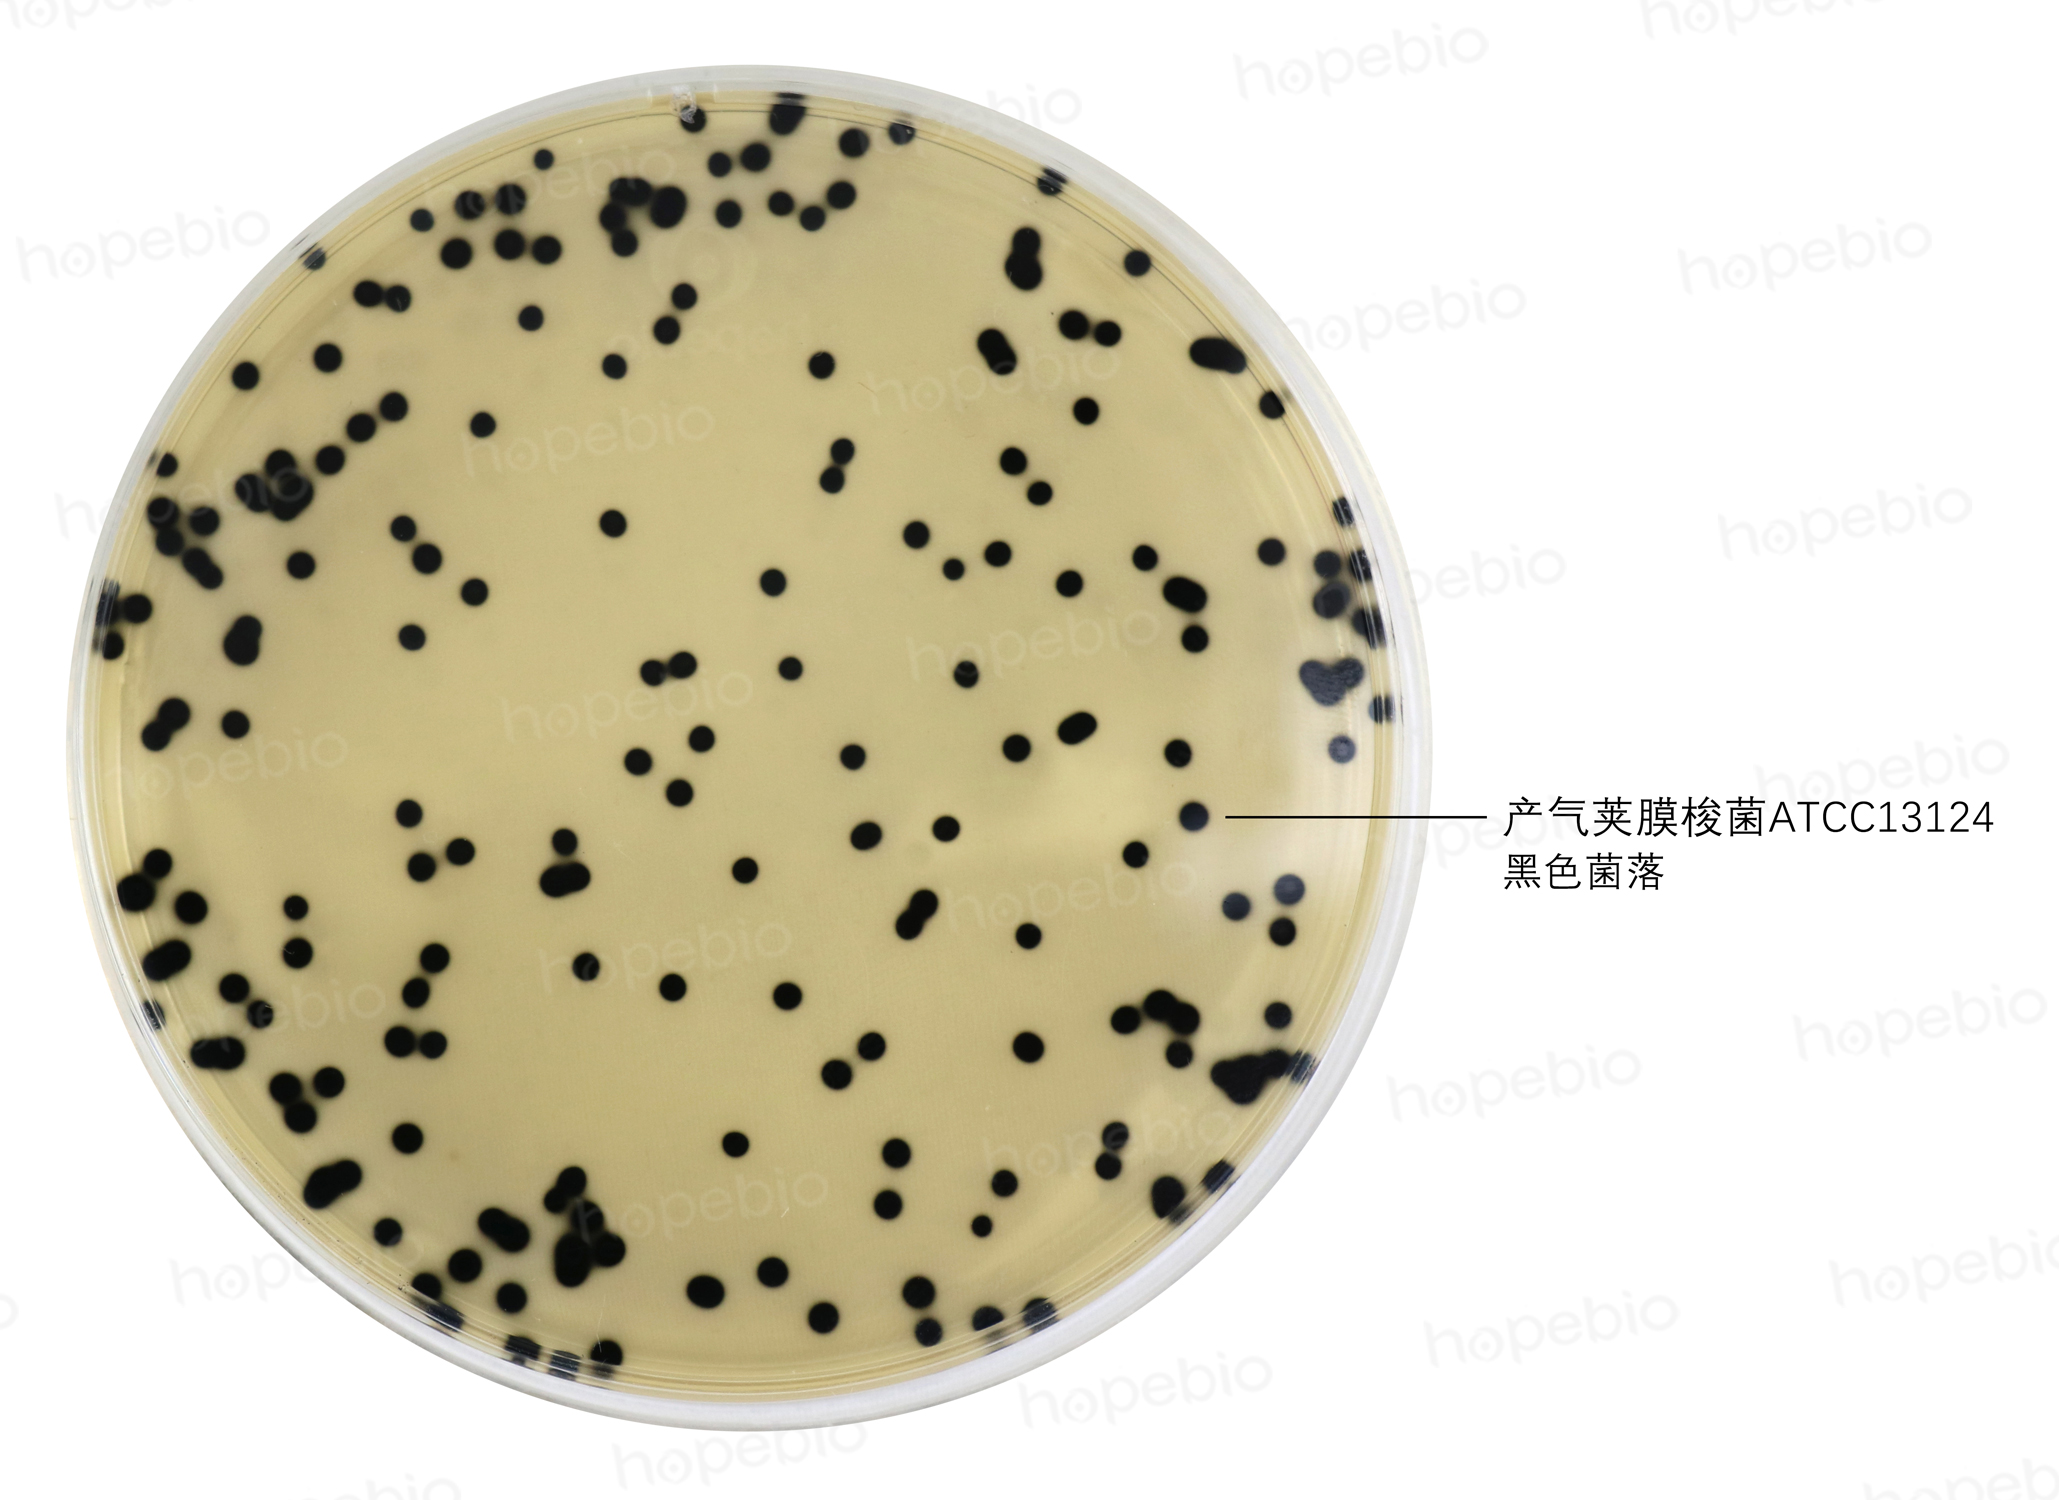

海博微信公众号
海博微信公众号
 海博天猫旗舰店
海博天猫旗舰店


 海博微信公众号
海博微信公众号
 海博天猫旗舰店
海博天猫旗舰店




一、产气荚膜梭菌简介
产气荚膜梭状芽孢杆菌(Clostridium perfringens)也叫魏氏梭菌,革兰氏阳性杆菌,厌氧生长,但不严格厌氧,对少量氧气具有一定的耐受性,有荚膜,无动力,对人和动物通常具有致病性,在血平板上能产生双溶血环,能在30℃-47℃快速生长,具有一定的耐热性。
二、产气荚膜梭菌的培养
该菌为厌氧菌,接种及培养需在厌氧工作站和厌氧培养箱(或厌氧罐、厌氧袋等设备)。若在空气中进行操作,通常建议时间控制在15min以内,长时间接触氧气易导致菌种死亡。
液体培养基常用硫乙醇酸盐流体或庖肉培养基,接种后在36±1℃培养18-24h即可,菌落生长旺盛时,通常可在培养基表面观察到大量气泡出现。也可使用GAM、梭菌增菌培养基、RCM、等厌氧菌培养基进行活化培养。
注:硫乙醇酸盐流体培养基的培养物通常要在24h内使用,超过24h菌种易开始衰减死亡,庖肉培养基则存活时间更久一些。
固体培养基可使用TSA、哥伦比亚琼脂、血平板等常规培养基,36±1℃厌氧培养24-48h,菌落直径可达2-5mm。平板使用前进行预除氧处理,则更易培养成功。也可使用RCM琼脂、GAM琼脂等厌氧菌培养基进行活化培养。
三、产气荚膜梭菌的分离与培养
1.分离培养与计数:产气荚膜梭菌对环丝氨酸、庆大霉素、多粘菌素、新霉素等药物不敏感,常用添加庆大霉素的哥伦比亚琼脂或添加环丝氨酸的TSC培养基在36±1℃培养24或48h进行分离培养或计数。产气荚膜梭菌可以产硫化氢,因此在TSC上菌落呈黑色。产气荚膜梭菌生长时,通常可以闻到较浓的臭味。
2.纯化培养:挑取TSC或哥伦比亚琼脂上的可疑菌落,接种至硫乙醇酸盐流体培养基中36±1℃培养18-24h,或划线至TSA/血平板36±1℃厌氧培养24-48h。
3.保存:产气荚膜梭菌为严格厌氧菌,相比于其他细菌更容易死亡,可使用甘油法或脱脂牛奶在-70℃以下长期冷冻保存。
四、鉴定
1.镜检:产气荚膜梭菌为革兰氏阳性杆菌,镜检时有时可见一端膨大(内含芽孢体)。
2.触酶试验:绝大多数梭菌属触酶试验为阴性,产气荚膜梭菌也是阴性。
3.暴烈发酵试验:产气荚膜梭菌特有的试验现象,在46±1℃水浴培养,发酵牛奶中的乳糖产生大量气体,同时凝固牛奶中的酪蛋白,大量气体带动凝固的酪蛋白上升,形成蜂窝状结构,但不出现变黑现象。

4.其他生化确认:产气荚膜梭菌可液化明胶,发酵乳糖,卵磷脂酶为阳性,在卵黄琼脂平板上菌落周围产生晕圈,动力试验为阴性,硝酸盐还原试验为阳性。
注:本文属海博生物原创,未经允许不得转载。
下一篇:简述酵母菌糖类发酵的试验方法
| 相关文章: | ||



